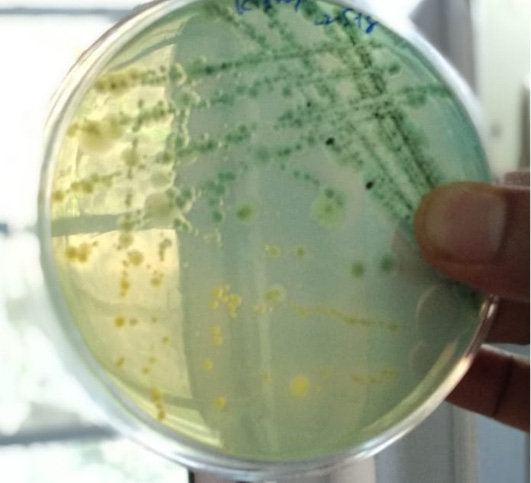
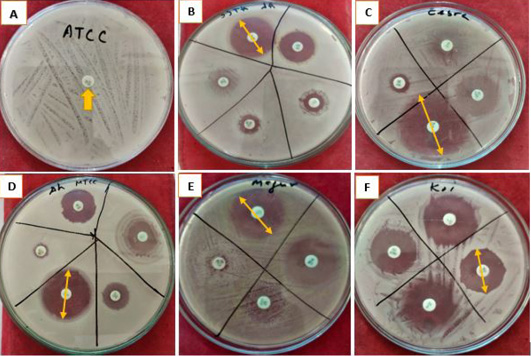

Advances in Animal and Veterinary Sciences
Map of Bangladesh showing the sapling site of walking catfish (Clarias batrachus). Letter: SB- Singari Beel.
Bar Diagram representing total 15 antibiotics and their length of inhibition. Letters: CIP, Ciprofloxacin; A/S, Ampicillin/Sulbactam; TE, Tetracycline; AT, Azithromycin; CTR, Ceftriaxone; LE, Levofloxacin; DO, Doxycycline; COT, Co-Trimoxazole; S, Streptomycin; O, Oxytetracycline; GEN, Gentamycin; OX, Oxacillin; E, Erythromycin; NV, Novobiocin; AMX, Amoxycillin.
Aeromonas hydrophila colonies grown on Rimler- Shotts (RS) selective medium.
Inhibition zone resulted using different antibiotics in pure culture of five A. hydrophila strains/isolates. Letters: A, Antibiotic sensitivity of A. hydrophila Strain ATCC 36562; B, Antibiotic Sensitivity of ATCC 36562; C, Antibiotic sensitivity of A. hydrophila isolated from Zebra fish (Danio rerio); D, Antibiotic sensitivity of Strain MTCC 1739; E, Antibiotic sensitivity of A. hydrophila isolated from walking catfish (Clarias batrachus); F, Antibiotic sensitivity of A. hydrophila isolated from Koi Carp (Cyprinus rubrofuscus). Yellow arrows showing the inhibition zone measured in (cm).